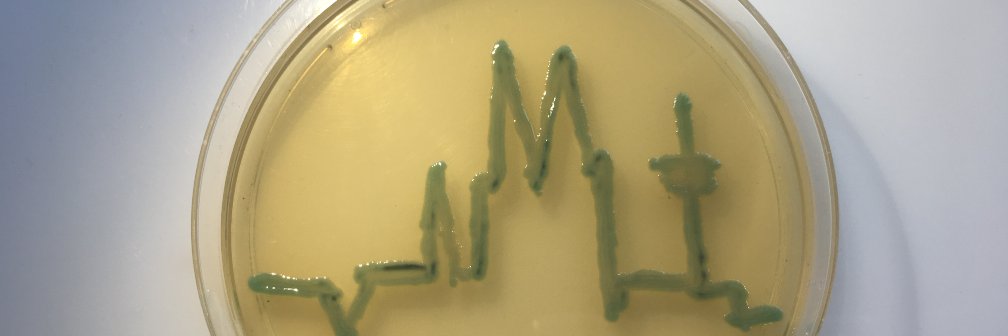
paul g higgins banner

paul g higgins retweetledi

🚀 As Artemis II astronauts journey around the Moon right now, our new paper asks a critical question:
What if a respiratory virus spreads inside a spacecraft?
📄 doi.org/10.1038/s41526…
#ArtemisII #NASA
English
paul g higgins
2.1K posts

@docpolski
#LaboratoryOfEskapology: investigating resistance mechanisms of Gram negatives, molecular epidemiology of ESKAPE organisms, and my pet organism N. gonorrhoeae

















🚨 President Trump has just released the data on what percentage of immigrants by country are receiving benefits Keir Starmer still refuses to do this in the UK



This study was SUPPRESSED They DON'T WANT YOU TO KNOW THE TRUTH



